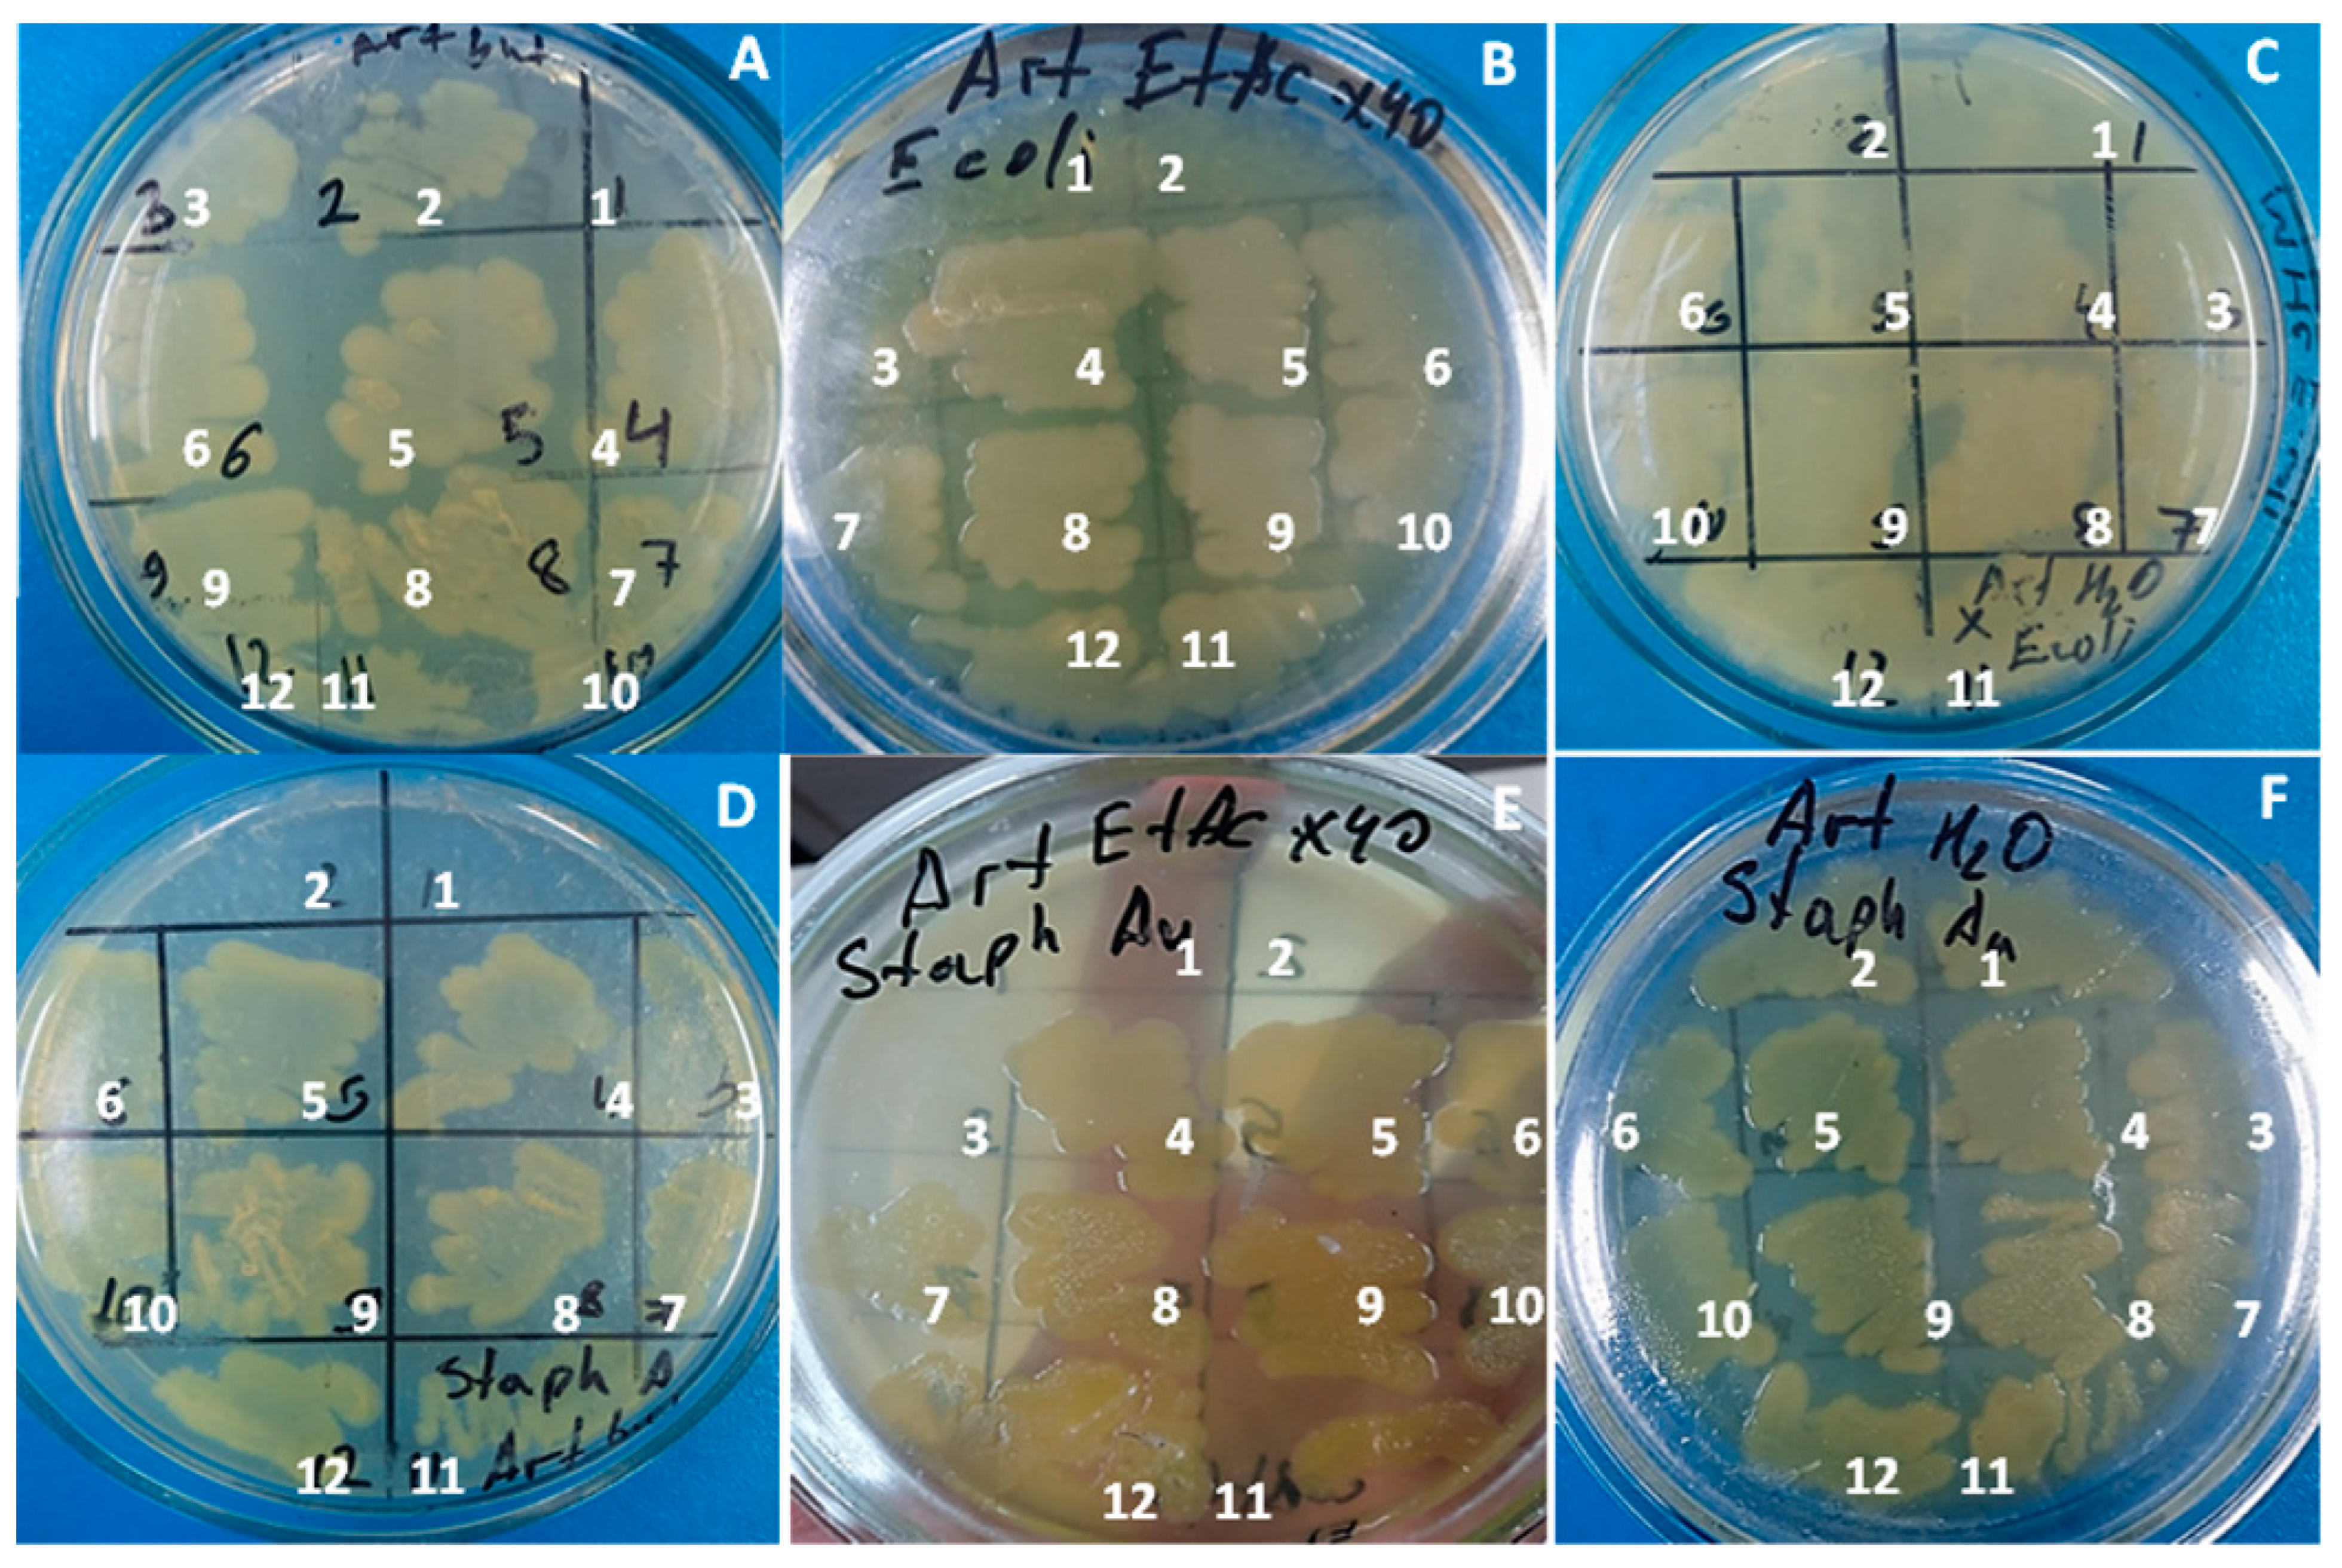
Processes 11 03041 g006

Antimicrobial Activity of Silver Nanoparticles Stabilized by Liposoluble Extract of Artemisia terrae-albae
Abstract
:1. Introduction
2. Materials and Methods
2.1. Plant Material
2.2. Extraction
2.3. AgNPs Stabilised by A. terrae-albae Extract Synthesis
2.4. Zeta Potential Measurement and Size Distribution
2.5. TEM
2.6. Assessment of Antibacterial Effects of Artemisia Extracts
2.7. Antimicrobial Activity of Plant Extract and AgNPs
3. Results and Discussion
3.1. AgNPs Synthesis and Characterization
3.2. Antimicrobial Activity of AgNPs and Extracts
4. Conclusions
Supplementary Materials
Author Contributions
Funding
Institutional Review Board Statement
Informed Consent Statement
Data Availability Statement
Conflicts of Interest
References
- Nigam, M.; Atanassova, M.; Mishra, A.P.; Pezzani, R.; Devkota, H.P.; Plygun, S.; Salehi, B.; Setzer, W.N.; Sharifi-Rad, J. Bioactive compounds and health benefits of Artemisia species. Nat. Prod. Commun. 2019, 14, 1934578–19850354. [Google Scholar] [CrossRef]
- Bora, K.S.; Sharma, A. The genus Artemisia: A comprehensive review. Pharm. Biol. 2011, 49, 101–109. [Google Scholar] [CrossRef] [PubMed]
- Siwan, D.; Nandave, D.; Nandave, M. Artemisia vulgaris Linn: An updated review on its multiple biological activities. Future J. Pharm. Sci. 2022, 8, 47. [Google Scholar] [CrossRef]
- Zhurinov, M.; Berillo, D.; Bazhykova, K.B.; Rakhimov, K.D.; Bekezhanova, T. An Estimation of the Antiviral Activity and Toxicity of Biologically Active Substances Obtained from the Raw Materials of Artemisia cina Berg. In Vitro and In Vivo. Molecules 2023, 28, 5413. [Google Scholar] [CrossRef] [PubMed]
- Janaćković, P.; Rajčević, N.; Gavrilović, M.; Novaković, J.; Giweli, A.; Stešević, D.; Marin, P.D. Essential oil composition of five Artemisia (Compositae) species in regards to chemophenetics. Biochem. Syst. Ecol. 2019, 87, 103960. [Google Scholar] [CrossRef]
- Ranjbar, M.; Naghavi, M.R.; Alizadeh, H. Chemical composition of the essential oils of Artemisia species from Iran: A comparative study using multivariate statistical analysis. J. Essent. Oil Res. 2020, 32, 361–371. [Google Scholar] [CrossRef]
- Ksibi, N.; Saada, M.; Yeddes, W.; Limam, H.; Tammar, S.; Wannes, W.A.; Labidi, N.; Hessini, K.; Dakhlaoui, S.; Frouja, O.; et al. Phytochemical Profile, Antioxidant and Antibacterial Activities of Artemisia absinthium L. Collected from Tunisian Regions. J. Mex. Chem. Soc. 2022, 66, 312–329. [Google Scholar] [CrossRef]
- Batiha, G.E.-S.; Olatunde, A.; El-Mleeh, A.; Hetta, H.F.; Al-Rejaie, S.; Alghamdi, S.; Zahoor, M.; Magdy Beshbishy, A.; Murata, T.; Zaragoza-Bastida, A.; et al. Bioactive compounds, pharmacological actions, and pharmacokinetics of wormwood (Artemisia absinthium). Antibiotics 2020, 9, 353. [Google Scholar] [CrossRef]
- Ahamad, J.; Mir, S.R.; Amin, S. A pharmacognostic review on Artemisia absinthium. Int. Res. J. Pharm. 2019, 10, 25–31. [Google Scholar] [CrossRef]
- Bordean, M.-E.; Muste, S.; Marțiș, G.S.; Mureșan, V.; Buican, B.C. Health effects of wormwood (Artemisia absinthium L.): From antioxidant to nutraceutical. J. Agroalim. Proc. Technol. 2021, 27, 211–218. [Google Scholar]
- Minda, D.; Ghiulai, R.; Banciu, C.D.; Pavel, I.Z.; Danciu, C.; Racoviceanu, R.; Soica, C.; Budu, O.D.; Muntean, D.; Diaconeasa, Z.; et al. Phytochemical profile; antioxidant; wound healing potential of three Artemisia species: In vitro and in ovo evaluation. Appl. Sci. 2022, 12, 1359. [Google Scholar] [CrossRef]
- Xiao, J.; Liu, P.; Hu, Y.; Liu, T.; Guo, Y.; Sun, P.; Zheng, J.; Ren, Z.; Wang, Y. Antiviral activities of Artemisia vulgaris L. extract against herpes simplex virus. Chin. Med. 2023, 18, 21. [Google Scholar] [CrossRef] [PubMed]
- Liu, P.; Zhong, L.; Xiao, J.; Hu, Y.; Liu, T.; Ren, Z.; Wang, Y.; Zheng, K. Ethanol extract from Artemisia argyi leaves inhibits HSV-1 infection by destroying the viral envelope. Virol. J. 2023, 20, 8. [Google Scholar] [CrossRef] [PubMed]
- Hbika, A.; Daoudi, N.E.; Bouyanzer, A.; Bouhrim, M.; Mohti, H.; Loukili, E.H.; Mechchate, H.; Al-Salahi, R.; Nasr, F.A.; Bnouham, M.; et al. Artemisia absinthium L. Aqueous and ethyl acetate extracts: Antioxidant effect and potential activity in vitro and in vivo against pancreatic α-amylase and intestinal α-glucosidase. Pharmaceutics 2022, 14, 481. [Google Scholar] [CrossRef]
- Zeb, S.; Ali, A.; Zaman, W.; Zeb, S.; Ali, S.; Ullah, F.; Shakoor, A. Pharmacology, taxonomy and phytochemistry of the genus Artemisia specifically from Pakistan: A comprehensive review. Pharm. Biomed. Res. 2019, 4, 1–12. [Google Scholar] [CrossRef]
- Ghanbar, F.; Mirzaie, A.; Ashrafi, F.; Noorbazargan, H.; Dalirsaber Jalali, M.; Salehi, S.; Sadat Shandiz, S.A. Antioxidant, antibacterial and anticancer properties of phyto-synthesised Artemisia quttensis Podlech extract mediated AgNPs. IET Nanobiotechnol. 2017, 11, 485–492. [Google Scholar] [CrossRef]
- Fard, N.N.; Noorbazargan, H.; Mirzaie, A.; Ch, M.H.; Moghimiyan, Z.; Rahimi, A. Biogenic synthesis of AgNPs using Artemisia oliveriana extract and their biological activities for an effective treatment of lung cancer. Artif. Cells Nanomed. Biotechnol. 2018, 46 (Suppl. S3), 1047–1058. [Google Scholar] [CrossRef]
- Taghavizadeh Yazdi, M.E.; Darroudi, M.; Amiri, M.S.; Hosseini, H.A.; Nourbakhsh, F.; Mashreghi, M.; Farjadi, M.; Mousavi Kouhi, S.M.; Mousavi, S.H. Anticancer, antimicrobial, and dye degradation activity of biosynthesised silver nanoparticle using Artemisia kopetdaghensis. Micro Nano Lett. 2020, 15, 1046–1050. [Google Scholar] [CrossRef]
- Balciunaitiene, A.; Viskelis, P.; Viskelis, J.; Streimikyte, P.; Liaudanskas, M.; Bartkiene, E.; Zavistanaviciute, P.; Zokaityte, E.; Starkute, V.; Ruzauskas, M.; et al. Green synthesis of silver nanoparticles using extract of Artemisia absinthium L., Humulus lupulus L. and Thymus vulgaris L., physico-chemical characterization, antimicrobial and antioxidant activity. Processes 2021, 9, 1304. [Google Scholar] [CrossRef]
- Zhangabay, Z.; Berillo, D. Antimicrobial and antioxidant activity of AgNPs stabilized with Calendula officinalis flower extract. Results Surf. Interfaces 2023, 11, 100109. [Google Scholar] [CrossRef]
- Khatoon, N.; Sharma, Y.; Sardar, M.; Manzoor, N. Mode of action and anti-Candida activity of Artemisia annua mediated-synthesized silver nanoparticles. J. Mycol. Médicale 2019, 29, 201–209. [Google Scholar] [CrossRef] [PubMed]
- Avitabile, E.; Senes, N.; D’avino, C.; Tsamesidis, I.; Pinna, A.; Medici, S.; Pantaleo, A. The potential antimalarial efficacy of hemocompatible silver nanoparticles from Artemisia species against P. falciparum parasite. PLoS ONE 2020, 15, e0238532. [Google Scholar] [CrossRef] [PubMed]
- Adhikari, A.; Lamichhane, L.; Adhikari, A.; Gyawali, G.; Acharya, D.; Baral, E.R.; Chhetri, K. Green Synthesis of Silver Nanoparticles Using Artemisia vulgaris Extract and Its Application toward Catalytic and Metal-Sensing Activity. Inorganics 2022, 10, 113. [Google Scholar] [CrossRef]
- Lim, S.H.; Ahn, E.-Y.; Park, Y. Green synthesis and catalytic activity of gold nanoparticles synthesized by Artemisia capillaris water extract. Nanoscale Res. Lett. 2016, 11, 474. [Google Scholar] [CrossRef] [PubMed]
- Aslany, S.; Tafvizi, F.; Naseh, V. Characterization and evaluation of cytotoxic and apoptotic effects of green synthesis of silver nanoparticles using Artemisia Ciniformis on human gastric adenocarcinoma. Mater. Today Commun. 2020, 24, 101011. [Google Scholar] [CrossRef]
- Al-Sheddi, E.S.; Alsohaibani, N.; bin Rshoud, N.; Al-Oqail, M.M.; Al-Massarani, S.M.; Farshori, N.N.; Malik, T.; Al-Khedhairy, A.A.; Siddiqui, M.A. Anticancer efficacy of green synthesized silver nanoparticles from Artemisia monosperma against human breast cancer cells. S. Afr. J. Bot. 2023, 160, 123–131. [Google Scholar] [CrossRef]
- El-Ashmouny, R.S.; Rady, M.H.; Merdan, B.A.; El-Sheikh, T.A.A.; Hassan, R.E.; E El Gohary, E.G. Larvicidal and pathological effects of green synthesized silver nanoparticles from Artemisia herba-alba against Spodoptera littoralis through feeding and contact application. Egypt. J. Basic Appl. Sci. 2022, 9, 239–253. [Google Scholar] [CrossRef]
- Berillo, D.; Arysbek, A. Chitosan Glutaraldegyde Cryogels for Wastewater Treatment and Extraction of Silver Nanoparticles. Processes 2023, 11, 1661. [Google Scholar] [CrossRef]
- Berillo, D.; Zakiruly, O.; Tolepova, A.; Baimenov, A.; Tauanov, Z. Antimicrobial activity of polymer with triclosan Bulletin of KazNU. Eurasian J. Ecol. 2023, 76, 56–70. [Google Scholar] [CrossRef]
- Rajakumar, G.; Rahuman, A.A. Larvicidal activity of synthesized silver nanoparticles using Eclipta prostrata leaf extract against filariasis and malaria vectors. Acta Trop. 2011, 118, 196–203. [Google Scholar] [CrossRef]
- Chahardoli, A.; Karimi, N.; Fattahi, A. Nigella arvensis leaf extract mediated green synthesis of silver nanoparticles: Their characteristic properties and biological efficacy. Adv. Powder Technol. 2018, 29, 202–210. [Google Scholar] [CrossRef]
- Adoni, M.; Yadam, M.; Gaddam, S.A.; Rayalacheruvu, U.; Kotakadi, V.S. Antimicrobial, antioxidant, and dye degradation properties of biosynthesized silver nanoparticles from Artemisia annua L. Lett. Appl. NanoBioSci. 2020, 10, 1981–1992. [Google Scholar]
- Baran, M.F. Synthesis and antimicrobial applications of silver nanoparticles from Artemisia absinthium plant. Biol. Chem. Res. 2019, 6, 96–103. [Google Scholar]
- Hu, L.; Yang, X.; Yin, J.; Rong, X.; Huang, X.; Yu, P.; He, Z.; Liu, Y. Combination of AgNPs and domiphen is antimicrobial against biofilms of common pathogens. Int. J. Nanomed. 2021, 7181–7194. [Google Scholar] [CrossRef] [PubMed]
- Xu, H.; Qu, F.; Xu, H.; Lai, W.; Andrew Wang, Y.; Aguilar, Z.P.; Wei, H. Role of reactive oxygen species in the antibacterial mechanism of silver nanoparticles on Escherichia coli O157: H7. Biometals 2012, 25, 45–53. [Google Scholar] [CrossRef]
- Aziz, A.T.; Alshehri, M.A.; Panneerselvam, C.; Murugan, K.; Trivedi, S.; Mahyoub, J.A.; Hassan, M.M.; Maggi, F.; Sut, S.; Dall’Acqua, S.; et al. The desert wormwood (Artemisia herba-alba)–From Arabian folk medicine to a source of green and effective nanoinsecticides against mosquito vectors. J. Photochem. Photobiol. B Biol. 2018, 180, 225–234. [Google Scholar] [CrossRef]
- Baghbani-Arani, F.; Movagharnia, R.; Sharifian, A.; Salehi, S.; Shandiz, S.A.S. Photo-catalytic, anti-bacterial, and anti-cancer properties of phyto-mediated synthesis of silver nanoparticles from Artemisia tournefortiana Rchb extract. J. Photochem. Photobiol. B Biol. 2017, 173, 640–649. [Google Scholar] [CrossRef]
- Ali, M.; Kim, B.; Belfield, K.D.; Norman, D.; Brennan, M.; Ali, G.S. Green synthesis and characterization of silver nanoparticles using Artemisia absinthium aqueous extract—A comprehensive study. Mater. Sci. Eng. C 2016, 58, 359–365. [Google Scholar] [CrossRef]
- Elemike, E.E.; Onwudiwe, D.C.; Ekennia, A.C.; Jordaan, A. Synthesis and characterisation of silver nanoparticles using leaf extract of Artemisia afra and their in vitro antimicrobial and antioxidant activities. IET Nanobiotechnol. 2018, 12, 722–726. [Google Scholar] [CrossRef]

| N of Sample | S. aureus (ATCC 6538) | Escherichia coli (ATCC 8739) | Pseudomonas aeruginosa ATCC 9027 | C. albicans (ATCC 10281) |
|---|---|---|---|---|
| AgNPs citrate etalon suspension | 0 | 15 ± 3 | 12 ± 2 | 18 ± 3 |
| EtAc extract ×15 | 11 ± 2 | 12 ± 2 | 12 ± 2 | 12 ± 2 |
| AgNPs@EtAc extract ×45 | 11 ± 3 | 0 | 11 ± 2 | 11 ± 2 |
| AgNPs@EtAc extract ×60 | 12 ± 3 | 20 ± 2 | 11 ± 2 | 20 ± 3 |
| EtAc extract ×8 | 0 | 11 ± 2 | 0 | 11 ± 2 |
| EtAc extract ×12 | 0 | 0 | 12 ± 3 | 11 ± 2 |
| EtAc extract ×16 | 0 | 0 | 11 ± 2 |
Disclaimer/Publisher’s Note: The statements, opinions and data contained in all publications are solely those of the individual author(s) and contributor(s) and not of MDPI and/or the editor(s). MDPI and/or the editor(s) disclaim responsibility for any injury to people or property resulting from any ideas, methods, instructions or products referred to in the content. |
© 2023 by the authors. Licensee MDPI, Basel, Switzerland. This article is an open access article distributed under the terms and conditions of the Creative Commons Attribution (CC BY) license (https://creativecommons.org/licenses/by/4.0/).
Share and Cite
Dyusebaeva, M.A.; Berillo, D.A.; Berganayeva, A.E.; Berganayeva, G.E.; Ibragimova, N.A.; Jumabayeva, S.M.; Kudaibergenov, N.Z.; Kanapiyeva, F.M.; Kirgizbayeva, A.A.; Vassilina, G.K. Antimicrobial Activity of Silver Nanoparticles Stabilized by Liposoluble Extract of Artemisia terrae-albae. Processes 2023, 11, 3041. https://doi.org/10.3390/pr11103041
Dyusebaeva MA, Berillo DA, Berganayeva AE, Berganayeva GE, Ibragimova NA, Jumabayeva SM, Kudaibergenov NZ, Kanapiyeva FM, Kirgizbayeva AA, Vassilina GK. Antimicrobial Activity of Silver Nanoparticles Stabilized by Liposoluble Extract of Artemisia terrae-albae. Processes. 2023; 11(10):3041. https://doi.org/10.3390/pr11103041
Chicago/Turabian StyleDyusebaeva, Moldyr A., Dmitriy A. Berillo, Alya E. Berganayeva, Gulzat E. Berganayeva, Nailya A. Ibragimova, Saltanat M. Jumabayeva, Nurbolat Z. Kudaibergenov, Fatima M. Kanapiyeva, Aray A. Kirgizbayeva, and Gulzira K. Vassilina. 2023. "Antimicrobial Activity of Silver Nanoparticles Stabilized by Liposoluble Extract of Artemisia terrae-albae" Processes 11, no. 10: 3041. https://doi.org/10.3390/pr11103041
APA StyleDyusebaeva, M. A., Berillo, D. A., Berganayeva, A. E., Berganayeva, G. E., Ibragimova, N. A., Jumabayeva, S. M., Kudaibergenov, N. Z., Kanapiyeva, F. M., Kirgizbayeva, A. A., & Vassilina, G. K. (2023). Antimicrobial Activity of Silver Nanoparticles Stabilized by Liposoluble Extract of Artemisia terrae-albae. Processes, 11(10), 3041. https://doi.org/10.3390/pr11103041

